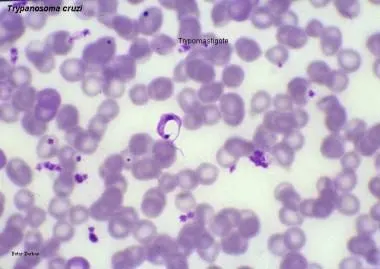
Chagas Disease Research - Epitope Prediction

Featured Projects

AI-Driven Sustainable Route Navigation
Eco-friendly routing system optimizing for reduced carbon emissions
View Details
Chagas Disease Research - Epitope Prediction
Machine learning approach to identify potential vaccine targets
View Details